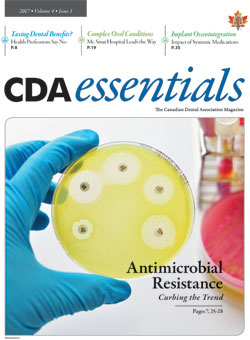

CDA Essentials is the official print publication of CDA, providing dialogue between the national association and the dental community. It is dedicated to keeping dentists informed about news, issues and clinically relevant information.
All Display and Classified Advertising rates and specifications available in the
2026 CDA Media Kit
Submit your classified insertion request here.
Contact: Michelle Bergeron, CDA Publications Specialist, at: mbergeron@cda-adc.ca
Volume 13 • 2026
|
Issue 2 |
|
|
|
||
|
|
|
Volume 12 • 2025
Volume 11 • 2024
Volume 10 • 2023
Volume 9 • 2022
Volume 8 • 2021
Volume 7 • 2020
Volume 6 • 2019
Volume 5 • 2018
Volume 4 • 2017
Volume 3 • 2016
Volume 2 • 2015
Volume 1 • 2014
ISSN 2292-7379 (Online)